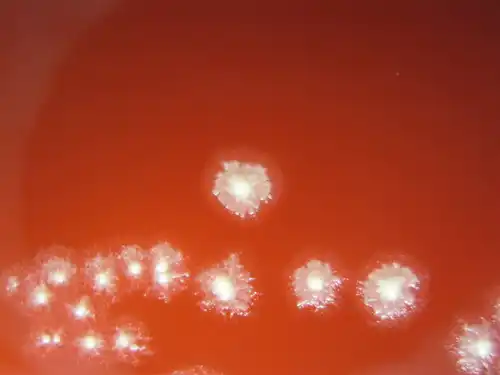
C.Tetani روی محیط بلاد آگار
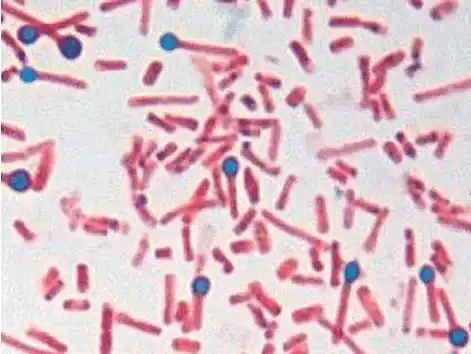
C. tetani زیر میکروسکوپ

مروری بر کلستریدیوم تتانی
بیماری کزاز (Tetanus) بهوسیله باکتری کلستریدیوم تتانی ایجاد میشود. این باکتری یک باسیل گرممثبت (Gram-positive bacillus) و بیهوازی اجباری (obligate anaerobe) است. کزاز یک بیماری عفونی است که با افزایش تونوس عضلانی (muscle tone) و بروز انقباضها و اسپاسمهای شدید عضلانی مشخص میشود. این علائم در نتیجهی ترشح تتانواسپاسمین (tetanospasmin)، یک نوروتوکسین بسیار قوی است که توسط C. tetani پس از ورود به بدن انسان تولید میشود.
مورفولوژی کلستریدیوم تتانی
C.Tetani ویژگیهای زیر را نشان میدهد:
- این باکتری باسیل باریکی است با طول تقریبی ۴ تا ۸ میکرومتر.
در حالت طبیعی، گرممثبت است، اما در کشتهای قدیمیتر ممکن است گرممتغیر (Gram-variable) یا حتی گرممنفی (Gram-negative) به نظر برسد. - این باسیل، راست و کشیده است، دیوارههای جانبی آن تقریباً موازی و انتهای سلولها گرد و صاف است. معمولاً بهصورت تکسلولی (single) و گاهی بهصورت زنجیرهای کوتاه (chains) دیده میشود.
- سلولهای باکتری دارای اسپورهای گرد، انتهایی (terminal) و متورم (bulging) هستند که به آن ظاهر چماقی (drumstick appearance) میدهد. اسپورها بهندرت حتی در نمونههای بالینی گرفتهشده از ضایعات یا در محیطهای کشت دیده میشوند.
- بهجز در تیپ VI، تمام سویههای tetani متحرک (motile) هستند، زیرا دارای تاژک (flagella) میباشند. سویهی تیپ VI فاقد تاژک است و بنابراین غیرمتحرک (non-motile) محسوب میشود.
- باکتریها دارای کپسول نیز هستند که به آنها در برابر عوامل محیطی و ایمنی میزبان مقاومت بیشتری میبخشد.

پراکندگی جغرافیایی کلستریدیوم تتانی
- بیماری کزاز تقریباً در سراسر جهان مشاهده میشود، اما شیوع آن در کشورهای در حال توسعه (developing nations) بسیار بیشتر است.
- این بیماری عمدتاً در مناطق کشاورزی، نواحی روستایی، اقلیمهای گرم و مرطوب و در فصول تابستان شایعتر است.
- کزاز میتواند افراد در هر سنی را مبتلا کند، اما نوزادان و نوجوانان بیشترین میزان بروز را دارند.
- بهطور کلی، بروز سالانهی جهانی کزاز بین ۰٫۵ تا ۱ میلیون مورد تخمین زده میشود که بیشتر آن در کشورهای فقیر و کمدرآمد رخ میدهد.
- در کشورهای کمتر توسعهیافته، حدود ۵۰ درصد از مرگهای ناشی از کزاز مربوط به کزاز نوزادی (neonatal tetanus) است.
زیستگاه (Habitat) کلستریدیوم تتانی
- ارگانیسمهای C.Tetani در خاک، مدفوع حیوانات و گاهی مدفوع انسان یافت میشوند، و همچنین میتوانند روی اشیای بیجان نیز حضور داشته باشند.
- اسپورهای این باکتری در شرایط خاص میتوانند برای سالها زنده بمانند و در برابر ضدعفونیکنندهها (disinfectants) و حتی جوشاندن در آب به مدت بیست دقیقه نیز مقاوم هستند.
منبع و راههای انتقال عفونت کلستریدیوم تتانی
- اسپورهای C.Tetani شکل عفونی (infectious form) این باکتری محسوب میشوند.
- منابع اصلی عفونت شامل خاک، مدفوع حیوانات، بهندرت مدفوع انسان، و همچنین اشیای بیجان آلوده به اسپورها هستند.
- عوامل خطر برای بروز کزاز نوزادی عبارتاند از: مادران واکسینهنشده، زایمان در منزل و بریدن ناصحیح بند ناف
- استفاده از موادی مانند مدفوع حیوانات، کرهی تصفیهشده (clarified butter) یا سایر مواد آلوده روی بند ناف نوزاد، از عوامل خطر اضافی محسوب میشوند.
- انواع زخمهایی که بیشتر مستعد ابتلا به کزاز هستند شامل موارد زیر میشوند:
- زخمهای بهشدت آلوده
- زخمهایی که در تماس با بزاق یا مدفوع قرار گرفتهاند
- زخمهای ستارهایشکل، ایسکمیک یا عفونی
- زخمهای عمیقتر از یک سانتیمتر
- زخمهای کندهشده، سوراخشده یا لهشده
بنابراین، کلستریدیوم تتانی با تولید اسپورهای مقاوم و ترشح نوروتوکسین مرگبار خود، عامل اصلی بروز کزاز در انسان است؛ بیماریای که هنوز هم در بسیاری از کشورهای کمدرآمد، بهویژه در نوزادان، از علل مهم مرگومیر محسوب میشود.
کشت باکتری کلستریدیوم تتانی
C.Tetani یک باکتری بیهوازی اجباری است؛ یعنی تنها در غیاب اکسیژن میتواند رشد کند. بهدلیل حساسیت شدید این باکتری به اکسیژن، در محیطهای دارای اکسیژن رشد نمیکند. بهترین رشد آن در دمای سی و هفت درجه سلسیوس (۳۷°C) و پیاچ حدود هفتوچهار (pH 7.4) اتفاق میافتد. C. tetani میتواند هم در محیطهای استاندارد کشت و هم در محیطهای غنیشده با سرم یا خون رشد کند.
محیط (Robertson Cooked Meat Medium) RCM
- C.Tetani بهخوبی در محیط RCM رشد میکند.
- علاوه بر ایجاد کدورت (turbidity) در محیط، باکتری مقداری گاز نیز تولید میکند.
- اگرچه گوشت درون محیط هضم نمیشود، اما در صورت انکوباسیون طولانیمدت، رنگ گوشت سیاه میشود.
محیط بلاد آگار (Blood Agar)
- C.Tetani روی محیط بلاد آگار موجب همولیز آلفا (alpha-hemolysis) در اطراف کلونیها میشود.
- در صورت انکوباسیون طولانیتر، باکتری آنزیمی به نام تتانولیزین (tetanolysin) تولید میکند؛ این ماده نوعی همولیزین است که همولیز آلفا را به همولیز بتا (beta-hemolysis) تبدیل مینماید.
- کلونیهای سطحی تمایل دارند در سراسر سطح آگار پخش شوند.
- C.Tetani یک لایه رشد بسیار نازک و شفاف روی سطح آگار ایجاد میکند که معمولاً فقط در حاشیه کلونیها قابل مشاهده است.
کشت در ژلاتین استب (Gelatin Stab Culture)
- C.Tetani در شرایط بیهوازی ژلاتین را مایع میکند
- در نتیجه، در طول انکوباسیون بیهوازی، الگوی رشدی شبیه درخت کاج یا درخت سرو در لوله ژلاتین استب مشاهده میشود.
محیط شیبدار آگار مغذی (Nutrient Agar Slope)
- زمانی که باکتری در آب تقطیر تجمعیافته در انتهای لوله حاوی آگار مغذی تلقیح شود و سپس بهمدت ۲۴ ساعت در شرایط بیهوازی انکوبه گردد، در بالای شیب داخل لوله کلونی خالص C.Tetani تشکیل میشود.
- این روش که به نام تکنیک فیلدز (Fildes technique) شناخته میشود، بهطور رایج برای جداسازی کلونیهای خالص C.Tetani مورد استفاده قرار میگیرد.
واکنشهای بیوشیمیایی کلستریدیوم تتانی
C.Tetani واکنشهای بیوشیمیایی زیر را نشان میدهد:
- دارای فعالیت پروتئولیتیک متوسط است، اما فعالیت ساکارولیتیک (saccharolytic activity) ندارد.
- هیچگونه تخمیر قندها انجام نمیدهد، گاز H₂S تولید نمیکند و اثری بر نیتراتها ندارد.
- در تست ایندول (Indole test) مثبت است، اما در تستهای (Methyl Red) MR و VP (Voges-Proskauer) منفی میباشد.
- در محیط MacConkey که حاوی نوترال رد (neutral red) است، tetani درخشش سبز مایل به زرد ایجاد میکند.
حساسیت به عوامل فیزیکی و شیمیایی
- اسپورهای C.Tetani در سویههای مختلف، مقاومت حرارتی متفاوتی نشان میدهند.
- جوشاندن در دمای ۱۰۰ درجه سانتیگراد به مدت ۱۰ تا ۱۵ دقیقه یا اتوکلاو کردن در ۱۲۱ درجه سانتیگراد به مدت ۲۰ دقیقه، بیشتر اسپورها را از بین میبرد.
- محلول یک درصد ید (1% iodine) یا ده درصد پراکسید هیدروژن (10% hydrogen peroxide) نیز میتواند اسپورها را نابود کند.
- با این حال، اسپورها در برابر بیشتر مواد ضدعفونیکننده مقاوم هستند.
- آنها توسط محلول پنج درصد فنول (5% phenol) یا ۰٫۱ درصد کلرید مرکوریک (0.1% mercuric chloride) از بین نمیروند و میتوانند سالها در خاک زنده بمانند.
تیپبندی
- C.Tetani بر اساس واکنش آگلوتیناسیون (agglutination) به ده تیپ سرولوژیک (serological types I تا X) تقسیمبندی میشود
- هر سویه (strain) از این باکتری، توکسین یکسانی تولید میکند.
- آنتیتوکسین استاندارد (standard antitoxin) قادر است تمام این سمها را خنثی (neutralize) نماید.
کلستریدیوم تتانی با وجود نیاز شدید به شرایط بیهوازی، قادر است در محیطهای آزمایشگاهی مختلف رشد کند و از خود رفتارهای بیوشیمیایی و مورفولوژیکی خاصی نشان دهد. مقاومت بسیار بالای اسپورهای آن در برابر گرما و مواد شیمیایی، عامل اصلی پایداری این باکتری در طبیعت و بروز عفونتهای کشنده در انسان است.
بیماری زایی و ایمنی در کلستریدیوم تتانی
C.Tetani یک باسیل غیرتهاجمی (noninvasive) است؛ یعنی خود باکتری بهتنهایی وارد بافتها نمیشود و تخریب بافتی مستقیمی ایجاد نمیکند. این باکتری تنها از طریق تولید سموم موجب بیماری میشود، و همین سموم، مهمترین عوامل ویرولانس یا بیماریزایی آن به شمار میآیند.
عوامل ویرولانس کلستریدیوم تتانی
C.Tetani سه نوع سم تولید میکند:
- تتانولیزین (tetanolysin)
- تتانواسپاسمین (tetanospasmin)
- نوروتوکسین غیر اسپاسمزا (neurotoxic or nonspasmogenic toxin)
از میان این سه، تتانولیزین و تتانواسپاسمین دو سم اصلی و شناختهشده هستند که از نظر ویژگیهای فارماکولوژیکی و آنتیژنی تفاوت دارند. در سالهای اخیر، نوع سوم یعنی سم غیر اسپاسمزا نیز شناسایی شده است، اگرچه نقش آن هنوز بهطور کامل مشخص نیست.
تتانواسپاسمین (Tetanospasmin)
تتانواسپاسمین همان سمی است که علائم بالینی بیماری کزاز را ایجاد میکند. این سم در مرحله ایستا (stationary phase) رشد باکتری سنتز میشود، اما تا زمان لیز شدن باکتریها آزاد نمیگردد.
- تتانواسپاسمین یک پروتئین تکزنجیرهای با وزن مولکولی حدود صد و پنجاهویک هزار دالتون (151,000 Da) است. پس از آزاد شدن از سلول باکتری، توسط یک پروتئاز درونی (endogenous protease) به دو زنجیره تقسیم میشود:
- زنجیره سبک (Light Chain, A) با وزن مولکولی حدود پنجاهودو هزار دالتون (52,000 Da)
- زنجیره سنگین (Heavy Chain, B) با وزن مولکولی حدود نودوسه هزار دالتون (93,000 Da)
- این دو زنجیره توسط پیوند دیسولفیدی (disulfide bond) و نیروهای غیرکوالانسی به یکدیگر متصل میمانند.
- این سم از نظر سمیت، بهشدت قوی و مرگبار است. حداقل دوز کشنده (Minimum Lethal Dose; MLD) در حیوانات بین پنجاه تا هفتاد و پنج در ده به توان منفی شش میلیگرم (50–75 × 10⁻⁶ mg) و در انسان حدود صد و سی نانوگرم (130 ng) است.
- گونههای مختلف جانوری درجههای متفاوتی از حساسیت نسبت به تتانواسپاسمین نشان میدهند.
- پرندگان و خزندگان مقاومت فوقالعادهای دارند.
- در مقابل، اسبها بیشترین حساسیت را دارند، و پس از آن بهترتیب خوکچه هندی، بز، و خرگوش حساستر هستند.
- این سم در نخاع از طریق مهار آزادسازی انتقالدهندههای عصبی مهاری مانند گاما آمینوبوتیریک اسید (GABA)، گلیسین (glycine) و سایر میانجیها، مهار سیناپسی (synaptic inhibition) را متوقف میکند.
در نتیجه، تحریکهای عصبی بدون کنترل در سراسر سیستم عصبی مرکزی (CNS) منتشر میشوند و منجر به اسپاسمهای مداوم و انقباضهای غیرارادی عضلانی میگردند.
- اتصال سم به گیرندههای عصبی غیرقابل برگشت است.
- سم کزاز از نظر ایمنیزایی آنتیژنیک ولی قابل بیخطرسازی است؛ با تیمار فرمالدهید به توکسوئید کزاز تبدیل میشود، که سمی ندارد اما خاصیت آنتیژنی خود را حفظ کرده و در واکسن کزاز استفاده میشود.
جزئیات عوامل ویرولانس C. tetani
- تتانواسپاسمین (Tetanospasmin)
- تتانواسپاسمین یک سم بسیار قوی و حساس به حرارت است.
- این سم آزادسازی انتقالدهندههای عصبی مهاری مانند GABA و گلیسین را مهار میکند و بدینترتیب مانع از مهار سیناپسی در نخاع میشود.
- در غیاب مهار عصبی، نورونهای حرکتی دچار تخلیه تحریککننده مداوم میشوند، که باعث بروز اسپاسمها و انقباضهای مداوم عضلانی میگردد.
- تتانولیزین (Tetanolysin)
- تتانولیزین یک همولیزین حساس به حرارت و اکسیژن است.
- از نظر آنتیژنی با همولیزینهای دیگر کلستریدیایی و استرپتولیزین (streptolysin O) O شباهت دارد
- با این حال، نقش بیماریزای آن (pathogenicity) مشخص نیست و بهنظر میرسد در بروز بیماری کزاز نقشی نداشته باشد
- نوروتوکسین غیر اسپاسمزا
- این سم نوعی نوروتوکسین فعال در محیط پیرامونی (peripherally active) است که اسپاسم ایجاد نمیکند
- این سم نوعی نوروتوکسین فعال در محیط پیرامونی (peripherally active) است که اسپاسم ایجاد نمیکند
بیماریزایی کلستریدیوم تتانی بهطور کامل ناشی از عملکرد سموم آن، بهویژه تتانواسپاسمین است که با اختلال در تعادل میان انتقالدهندههای عصبی تحریکی و مهاری در سیستم عصبی مرکزی، موجب بروز انقباضهای شدید، اسپاسمهای مکرر، و علائم کلاسیک بیماری کزاز میشود.
بیماریزایی کزاز (Tetanus)
بیماری کزاز زمانی ایجاد میشود که اسپورهای کلستریدیوم تتانی وارد بدن انسان شوند. در شرایط بیهوازی مناسب، این اسپورها جوانه میزنند و به سلولهای رویشی فعال (vegetative forms) تبدیل میشوند. سپس این سلولهای فعال، سموم اصلی باکتری یعنی تتانواسپاسمین (tetanospasmin) و تتانولیزین (tetanolysin) را تولید میکنند.

زخمهایی که دارای پتانسیل اکسایش–کاهش پایین هستند، محیطی ایدهآل برای رشد بیهوازی فراهم میکنند؛ از جمله:
- بافتهای مرده یا نکروتیک
- وجود اجسام خارجی در زخم
- عفونتهای فعال موضعی
در چنین شرایطی، باکتری C. tetani رشد کرده و سم تتانواسپاسمین را آزاد میکند. این سم در محل اتصال عصبی–عضلانی در محیط پیرامونی جذب شده و بهصورت حرکت مرکزگرا از راه اعصاب محیطی به نورونهای سیستم عصبی مرکزی منتقل میشود.
مکانیسم مولکولی عمل سم تتانواسپاسمین
- زنجیره سنگین سم با وزن مولکولی حدود صد کیلو دالتون مسئول انتقال پروتئین و اتصال اختصاصی به سلولهای مغزی است
- زنجیره سبک عملکردی آنزیمی دارد و آزادسازی انتقالدهندههای عصبی مهاری مانند گاما آمینوبوتیریک اسید و گلیسین را مهار میکند
در نتیجه، واکنش مهاری حرکتی نسبت به تحریکات حسی از کار میافتد و تعادل میان تحریک و مهار عصبی از بین میرود.
به دلیل حذف مهار متقابل، عضلات آگونیست و آنتاگونیست بهطور همزمان دچار انقباض میشوند و این وضعیت منجر به اسپاسم عمومی عضلانی میگردد.
انتقال و اثر سم بر سیستم عصبی
اعصاب محیطی کوتاهتر، سم را سریعتر به سیستم عصبی مرکزی میرسانند، که این امر باعث بروز تغییر حالت چهره، سفتی عضلات گردن و کمر میشود.
شدت سمیت تتانواسپاسمین و نوع تظاهر بالینی آن بستگی به راه ورود سم به بدن دارد:
- تزریق داخلعصبی یا مستقیم به سیستم عصبی مرکزی، مرگبارترین شکل ورود سم است.
- تزریق وریدی، عضلانی یا زیرجلدی نیز مؤثر است، اما شدت اثر کمتری دارد.
- ورود خوراکی بیاثر است، زیرا سم در دستگاه گوارش توسط آنزیمهای گوارشی تخریب میشود.
کزاز تجربی در حیوانات
در حیوانات آزمایشگاهی مانند موش، نوع و شدت کزاز نیز به راه تزریق سم بستگی دارد.
تزریق درونعضلانی سم
- نتیجه، بروز کزاز صعودی است
وقتی سم در عضلهی یکی از اندامهای خلفی تزریق میشود، اسپاسم تونیک ابتدا در همان اندام آغاز میگردد. - این پدیده ناشی از اثر مستقیم سم بر بخش مربوطه از نخاع است.
- هنگامی که سم وارد اتصالات سیناپسی میشود، با مهار آزادسازی ناقلهای عصبی، انتقال مهارکنندهی پیام عصبی را متوقف میکند.
- در نتیجه، عصب به ارسال پیاپی پیام ادامه میدهد و موجب اسپاسم یا انقباض مکرر عضلات آسیبدیده میشود.
- سفتی عضلانی نخستین علامت بیماری است، و معمولاً ماهیچههای فک اولین نواحی هستند که دچار علائم میشوند.
- این حالت با عنوان قفل فک شناخته میشود. با پیشرفت بیماری، سایر گروههای عضلانی نیز دچار اسپاسم میشوند.
- اگرچه این اسپاسمها کوتاهمدتاند، اما به دفعات تکرار میشوند و موجب درد شدید و خستگی مفرط میگردند. این حالت بهعنوان کزاز موضعی شناخته میشود.
- با گسترش سم بهسمت نخاع، کزاز صعودی ایجاد میشود که در ادامه اندام خلفی مقابل، تنه و اندامهای جلویی را نیز درگیر میکند.
تزریق وریدی سم
- این روش منجر به بروز کزاز نزولی میشود
در این حالت، سفتی و اسپاسم ابتدا در عضلات سر و گردن ظاهر میشود و سپس بهصورت نزولی به سایر بخشهای بدن گسترش مییابد — مشابه همان الگویی که در کزاز انسانی مشاهده میشود.
بیماری کزاز حاصل ورود اسپورهای C. tetani به بدن و تولید سم نوروتوکسیک آن است. سم از محل زخم بهصورت مرکزگرا به سیستم عصبی مرکزی منتقل میشود، انتقالدهندههای عصبی مهاری را مهار میکند، و با از بین بردن تعادل میان تحریک و مهار عصبی، موجب انقباضهای ممتد و اسپاسمهای دردناک عضلات میشود — وضعیتی که مشخصهی بارز بیماری کزاز است.
ایمنی میزبان
در بدن، آنتیبادیهای محافظتی علیه سم کزاز تولید میشوند. این آنتیبادیها بهطور اختصاصی با سم آزاد موجود در گردش خون ترکیب میشوند و فعالیت سمی آن را مهار میکنند. این فرایند یکی از مؤثرترین مکانیسمهای دفاعی سیستم ایمنی است که از طریق تولید ایمنوگلوبولینهای خنثیکننده در پاسخ به ورود آنتیژن انجام میشود.
- بالاترین میزان ایمنی محافظتی در برابر کزاز در میان کودکان و افراد بین شش تا سیونه سال دیده میشود. این گروههای سنی معمولاً به دلیل واکسیناسیون کامل دوران کودکی، بیشترین میزان ایمنی مؤثر را دارند.
- ایمنی محافظتی در برابر کزاز با افزایش سن کاهش مییابد. مطالعات سرولوژیک در کشورهای مختلف نشان دادهاند که سطح ایمنی در افراد مسن بهویژه در سالمندان کاهش چشمگیری دارد. حدود پنجاه درصد از افراد بالای پنجاه سال فاقد ایمنی هستند، زیرا یا هرگز واکسینه نشدهاند یا دوز یادآور واکسن را دریافت نکردهاند. این امر اهمیت فوقالعادهی تزریق دورهای واکسن یادآور را نشان میدهد، چراکه سطح آنتیبادی در طول زمان کاهش مییابد.
- ابتلا به کزاز ایمنی ایجاد نمیکند، زیرا مقدار سمی که در جریان بیماری آزاد میشود بسیار اندک است و توان تحریک پاسخ ایمنی مؤثر را ندارد. بنابراین، افرادی که از بیماری جان سالم به در میبرند باید بهطور فعال با تزریق توکسوئید کزاز واکسینه شوند تا از عود مجدد بیماری جلوگیری شود.
سندرمهای بالینی ناشی از کلستریدیوم تتانی
دورهی کمون یا نهفتگی کزاز، که فاصلهی میان ورود باکتری به بدن تا بروز نخستین علائم بیماری است، از چند روز تا چند هفته متغیر است، اما معمولاً بین شش تا دوازده روز طول میکشد. این بازهی زمانی به عوامل متعددی وابسته است، از جمله:
- فاصلهی میان محل زخم اولیه و سیستم عصبی مرکزی،
- مقدار باکتری واردشده به بدن،
- توان سمی باکتری در تولید توکسین،
- و وضعیت ایمنی میزبان در زمان آلودگی
C.Tetani میتواند چهار نوع اصلی از بیماری کزاز را ایجاد کند:
- کزاز عمومی
- کزاز نوزادی
- کزاز موضعی
- کزاز سفالیک
کزاز عمومی
کزاز عمومی شایعترین نوع این بیماری است. در این حالت، سمی که در محل زخم آزاد میشود، از طریق عروق لنفاوی و جریان خون به پایانههای عصبی متعدد منتقل میگردد. دلیل این انتشار غیرمستقیم آن است که سد خونی–مغزی اجازهی عبور مستقیم سم به سیستم عصبی مرکزی را نمیدهد. در این نوع، شدت زخمها از آسیبهای سطحی تا لهشدگیهای شدید متغیر است.
- دورهی کمون بیماری بین هفت تا بیستویک روز متغیر است و با میزان نزدیکی محل زخم به سیستم عصبی مرکزی ارتباط مستقیم دارد؛ هرچه زخم به نواحی عصبی نزدیکتر باشد، بروز علائم سریعتر و شدیدتر خواهد بود.
- درگیری عضلهی جونده باعث بروز قفل فک یا تریسموس میشود که شایعترین و نخستین علامت بیماری است. این علامت بهدلیل مهار ناقلهای عصبی مهاری در نورونهای حرکتی ایجاد میشود.
- سایر نشانههای اولیه شامل دشواری در بلع، تحریکپذیری بالا و بیقراری هستند که بهتدریج بهصورت سفتی عمومی عضلات ظاهر میشوند
- با پیشرفت بیماری، بیمار دچار سفتی گستردهی عضلات و اسپاسمهای انعکاسی متناوب میشود که در پاسخ به محرکهایی چون صدا یا لمس بروز میکنند. این واکنشها ناشی از افزایش بیشازحد تحریکپذیری نورونهای حرکتی در نخاع است.
- در مراحل پیشرفته، وضعیتی به نام اپیستوتونوس ایجاد میشود که در آن بازوها به سمت بدن خم و جمع میشوند، مشتها گره میخورند، و پاها بهطور غیرارادی کشیده و منقبض میگردند. این حالت ناشی از انقباض تونیک و همزمان گروههای عضلانی متضاد است.
- در هنگام بروز اسپاسمها، بیماران دچار درد شدید و غیرقابل تحمل میشوند، در حالیکه هوشیاری آنها کاملاً حفظ میگردد. در این شرایط ممکن است شکستگی استخوان، پارگی تاندون یا نارسایی ناگهانی تنفسی رخ دهد که تهدیدکنندهی حیات است.
- یکی از علائم کلاسیک این بیماری، پدیدهی «ریسوس ساردونیکوس» یا «لبخند تمسخرآمیز» است که بهدلیل انقباض مداوم عضلات صورت ایجاد میشود و چهرهای خاص و خشک به بیمار میدهد.
- به علت زمان مورد نیاز برای انتقال پادزهر درون آکسونها، ممکن است علائم بیماری تا دو هفته پس از تزریق آنتیتوکسین همچنان رو به وخامت برود، چراکه سم قبلاً به نورونها متصل شده است و این اتصال برگشتپذیر نیست.
- پیشآگهی بیماری به سه عامل اصلی بستگی دارد:
- طول دورهی کمون،
- فاصلهی زمانی بین آلودگی اولیه و بروز نخستین علامت،
- و فاصلهی میان بروز اولین علامت تا آغاز نخستین اسپاسم تتانیک.
بهطور معمول، هرچه دورهی کمون کوتاهتر باشد، شدت بیماری بیشتر و خطر مرگ بالاتر است. در مقابل، دورهی کمون طولانیتر معمولاً با پیشآگهی بهتر همراه است. بهبودی کامل اغلب بین دو تا چهار ماه طول میکشد و نیازمند مراقبت مستمر، حمایت تنفسی و درمان دارویی دقیق است.
در مجموع، ایمنی علیه کزاز تنها از طریق واکسیناسیون فعال و منظم حاصل میشود، و از آنجا که بیماری ایمنی طبیعی ایجاد نمیکند، حفظ ایمنی مادامالعمر منوط به دریافت دورهای دوزهای یادآور واکسن است.
کزاز نوزادی
- کزاز نوزادی یکی از اشکال گسترده و خطرناک کزاز است که بر اثر عفونت در نوزادان ایجاد میشود. این نوع کزاز بیشتر در کشورهای در حال توسعه دیده میشود و از مهمترین علل مرگومیر نوزادان به شمار میرود
- عفونت معمولاً زمانی رخ میدهد که برای بریدن یا بستن بند ناف از تیغ، چاقو یا وسایل آلوده استفاده شود، بهویژه در نوزادانی که مادر آنها واکسینه نشده است. در این شرایط، اسپورهای باکتری از طریق بند ناف وارد بدن نوزاد میشوند.
- معمولاً در پایان هفتهی اول زندگی، نوزادان آلوده دچار تحریکپذیری، تغذیهی ضعیف و اسپاسمهای شدید عضلانی میشوند. این نشانهها بهسرعت پیشرفت کرده و اغلب با سفتی عمومی بدن و دشواری در تنفس همراهاند.
- پیشآگهی بیماری بسیار نامطلوب است و میزان مرگومیر آن بیش از هفتاد درصد گزارش شده است. حتی با درمانهای حمایتی، شانس بقا در بسیاری از مناطق پایین باقی مانده است.
کزاز موضعی
- کزاز موضعی یک نوع نادر از بیماری است که در آن عفونت به یک اندام خاص محدود میشود. بیماری تنها اعصابی را درگیر میکند که عضلات همان ناحیه را عصبدهی میکنند.
- این حالت به دلیل اختلال در عملکرد نورونهای واسطهای مهارکنندهی نورونهای حرکتی در عضلات مبتلا ایجاد میشود و با سفتی موضعی و اسپاسم محدود مشخص است.
- در این نوع، سیستم عصبی مرکزی درگیر نمیشود و میزان مرگومیر بسیار پایین است. با این حال، در برخی موارد، کزاز موضعی میتواند به شکل عمومی پیشرفت کند.
کزاز سفالیک
- کزاز سفالیک در واقع نوعی از کزاز موضعی است که در ناحیهی سر و گردن بروز میکند.
- این شکل معمولاً بر اثر آسیبهای ناحیهی سر یا عفونت گوش میانی ایجاد میشود
- دورهی کمون بیماری بسیار کوتاه است و معمولاً بین یک تا دو روز طول میکشد.
- علائم ممکن است بهصورت درگیری جداگانه یا ترکیبی عصبهای حرکتی مغزی، بهویژه عصب شمارهی هفتم (عصب چهره)، بروز کنند. این وضعیت اغلب با پیشآگهی نامطلوب همراه است و در صورت عدم درمان سریع میتواند به شکل عمومی بیماری تبدیل شود.
تشخیص آزمایشگاهی کلستریدیوم تتانی
تشخیص آزمایشگاهی کزاز معمولاً بر اساس تظاهرات بالینی بیماری و در نظر گرفتن احتمال آلودگی باکتری کلستریدیوم پرفرینجنس انجام میشود. آزمایشگاهها عمدتاً برای تأیید تشخیص بالینی از تستهای میکروبی استفاده میکنند، زیرا ویژگیهای بالینی اغلب بهتنهایی برای تشخیص کافی هستند.
نمونهها
- نمونههای مورد بررسی شامل بافتهای نکروتیک یا مردهای است که از عمق زخم جدا میشوند.
- نمونههای سطحی مانند سوآب زخم برای تشخیص مناسب نیستند، زیرا معمولاً فاقد باکتری زنده هستند یا در تماس با اکسیژن، ارگانیسم از بین میرود
میکروسکوپی
رنگآمیزی گرم بر روی اسمیرهای C. tetani گاهی مفید است، اما در بیشتر موارد دقت کافی ندارد.
وجود باسیلهایی با ظاهر چماقیشکل (drumstick appearance) در بافت زخم برای تشخیص قطعی کزاز کافی نیست، زیرا:
- ممکن است برخی زخمها حاوی C.Tetani باشند بدون اینکه بیمار به کزاز مبتلا شود.
- همچنین، از نظر شکل ظاهری، C.Tetani ممکن است با سایر گونههای کلستریدیوم مانند C. tetanomorphum یا C. sphenoides اشتباه گرفته شود.
کشت
- نمونهها روی محیط آگار خون کشت داده شده و به مدت ۲۴ تا ۴۸ ساعت در شرایط بیهوازی انکوبه میشوند.
- C.Tetani در محیط کشت رشد پخشی دارد و سطح محیط را بهطور کامل میپوشاند.
- همچنین، نمونهها در سه لوله حاوی محیط RCM تلقیح میشوند: یکی از لولهها در دمای ۸۰ درجهی سانتیگراد به مدت ۱۵ دقیقه حرارت داده میشود، دیگری برای ۵ دقیقه، و لولهی سوم برای ۲۴ تا ۴۸ ساعت در دمای ۳۷ درجه انکوبه میگردد.
- در ادامه، هر روز تا چهار روز از این کشتها روی آگار خون کشت ثانویه داده میشود تا رشد خالص بهدست آید. C.Tetani معمولاً از حاشیههای کلونیهای پخششوندهی آگار خون بهصورت خالص جدا میشود.
- با این حال، به دلیل تعداد اندک باکتریها در زخم و مرگ بخشی از آنها در تماس با هوا، تنها حدود سی درصد از موارد کزاز نتیجهی کشت مثبت دارند.
شناسایی باکتری
- ویژگیهای متمایز C.Tetani شامل شکل ظاهری باکتری، الگوی رشد در محیط کشت، و توانایی تولید سم است.
آزمون سمیتزایی
سویههای C. tetani از نظر تولید سم با روشهای مختلف بررسی میشوند.
آزمون خنثیسازی در محیط آگار خون
- این آزمون بر روی آگار خونی با غلظت چهار درصد انجام میشود. افزایش غلظت آگار باعث جلوگیری از پخششدگی بیش از حد C.Tetani در محیط میگردد.
- نیمی از محیط حاوی آنتیتوکسین کزاز با غلظت ۱۵۰۰ واحد در میلیلیتر است و نیم دیگر فاقد آنتیتوکسین میباشد.
- هر دو نیمه با سویههای C.Tetani تلقیح شده و بهمدت ۴۸ ساعت در شرایط بیهوازی انکوبه میشوند.
- در بخش بدون آنتیتوکسین، کلونیهای باکتری خاصیت همولیتیک نشان میدهند، در حالیکه در بخش حاوی آنتیتوکسین، همولیز دیده نمیشود.
- دلیل این تفاوت، مهار فعالیت همولیتیک سم توسط آنتیتوکسین موجود در محیط است.
- این آزمایش در شناسایی سویهی C.Tetani مفید است، اما بهدلیل حساسیت پایین، برای تشخیص قطعی بهتنهایی قابل اعتماد نیست.
آزمون خنثیسازی در بدن زنده (In vivo neutralization test in mice)
- در این آزمون، مقدار ۰٫۲ میلیلیتر از کشت گوشت پختهی دو تا چهار روزهی کلستریدیوم تتانی در ناحیهی ریشهی دم دو موش تزریق میشود. یکی از این موشها، یک ساعت پیش از تزریق با دریافت ۱۰۰۰ واحد آنتیتوکسین کزاز واکسینه میشود و بهعنوان موش شاهد در نظر گرفته میشود.
- موش دیگر بدون دریافت آنتیتوکسین باقی میماند و بهعنوان موش آزمایشی مورد بررسی قرار میگیرد. در موش آزمایشی، در اثر سم تتانواسپاسمین تولیدشده توسط C.Tetani، طی ۱۲ تا ۲۴ ساعت پس از تزریق، علائم کزاز صعودی بروز میکند.
- علائم ابتدا با سفتی در دم آغاز میشود و بهسرعت به پای همان سمت، سپس به پای مقابل، تنه و اندامهای جلویی گسترش مییابد.
- معمولاً حیوان طی ۴۸ ساعت میمیرد، در حالیکه موش شاهد واکسینهشده هیچ علامتی نشان نمیدهد.
بنابراین، این آزمون حیوانی یک روش معتبر برای تأیید شناسایی کلونی بهعنوان C.Tetani محسوب میشود.
تشخیص سرولوژیک (Serodiagnosis)
- در سرم بیماران مبتلا، نه آنتیبادی بر ضد سم کزاز و نه خود سم وجود دارد؛ بنابراین، انجام آزمایشهای سرولوژیک برای تشخیص بیماری کاربردی ندارد و معمولاً انجام نمیشود.
سایر آزمونها – آزمون اسپاتولا (The spatula test)
این آزمون روشی ساده و مفید برای تشخیص سریع کزاز در کنار بستر بیمار است. در این روش، با استفاده از اسپاتولا یا تیغهی زبان، بخش دهانی–حلقی بیمار بهآرامی تحریک میشود.
در افراد سالم، این تحریک باعث ایجاد رفلکس تهوع و تلاش بیمار برای خارجکردن اسپاتولا میشود که نشانهی منفی بودن آزمون است.
در بیماران مبتلا به کزاز، برعکس، تماس اسپاتولا موجب انقباض انعکاسی عضلات فک (ماستر) و گازگرفتن اسپاتولا میشود که آزمون را مثبت نشان میدهد.
این تست از نظر دقت تشخیصی بسیار ارزشمند است و ۱۰۰ درصد حساسیت و ۱۰۰ درصد ویژگی تشخیصی دارد.
ویژگیهای شناساییکنندهی کلستریدیوم تتانی
- لایهی رشد بسیار نازک و شفاف که تمایل دارد تمام سطح محیط آگار را بپوشاند.
- تولید کلونیهای همولیتیک نوع آلفا در آغاز کشت روی محیط خون، که پس از انکوباسیون طولانیتر، در اثر سنتز تتانولیزین به همولیز نوع بتا تبدیل میشوند.
- در اسمیر رنگآمیزی گرمِ کلونیها، باسیلهای گرممثبت با اسپورهای انتهایی برجسته دیده میشوند که ظاهر چماقیشکل دارند.
- باکتریها (بهجز تیپ شش) متحرک و دارای کپسول هستند.
- قندها را تخمیر نمیکنند.
- آزمون سمیت در موشها، یک روش معتبر برای شناسایی کلونی بهعنوان C.Tetani است.
درمان عفونت ناشی از کلستریدیوم تتانی
درمان کزاز شامل چند مرحلهی اساسی است که باید همزمان انجام شوند:
- مراقبت حمایتی اولیه
- دبریدمان و پاکسازی زخم
- توقف تولید سم
- خنثیسازی سمهای آزادنشده
- کنترل علائم بالینی
- مدیریت عوارض ثانویه
درمان معمولاً ترکیبی از آنتیبیوتیکها و ایمنوگلوبولین انسانی است.
درمان آنتیبیوتیکی
- آنتیبیوتیکها برای مهار رشد و تکثیر C.Tetani در زخم استفاده میشوند، تا تولید و آزادسازی سم متوقف شود.
- داروی انتخابی فعلی، مترونیدازول است؛ در حالیکه پنیسیلین بهعنوان جایگزین مورد استفاده قرار میگیرد.
- در بیمارانی که نسبت به پنیسیلین یا مترونیدازول حساسیت دارند، تتراسایکلین میتواند بهعنوان داروی جایگزین تجویز شود.
- سایر آنتیبیوتیکهای مؤثر در درمان کزاز شامل کلیندامایسین، اریترومایسین، و وانکومایسین هستند.
درمان با ایمنوگلوبولین انسانی (Human immunoglobulin therapy)
- ایمنوگلوبولین انسانی ضد کزاز برای خنثیسازی سم آزاد نشده و جلوگیری از رسیدن آن به سیستم عصبی مرکزی تجویز میشود.
- در زمان تشخیص، دوز واحدی بین ۳۰۰۰ تا ۶۰۰۰ واحد بینالمللی (IU) بهصورت تزریق عضلانی به کودکان و بزرگسالان داده میشود.
- در موارد کزاز نوزادی، دوز ۵۰۰ واحدی مؤثر و ایمن گزارش شده است.
- در مناطقی که ایمنوگلوبولین انسانی در دسترس نیست، از آنتیتوکسین اسبی (Equine Tetanus Antitoxin – ATS) استفاده میشود.
- این آنتیتوکسین پس از انجام آزمایش حساسیت و در صورت نیاز با روش حساسیتزدایی، بهصورت تزریق عضلانی با دوز ۵۰٬۰۰۰ تا ۱۰۰٬۰۰۰ واحد تجویز میشود. معمولاً بخشی از دوز (۲۰٬۰۰۰ واحد) بهصورت وریدی تزریق میشود تا اثر سریعتری داشته باشد.
همچنین بخوانید:
- ویروس HMPV چیست؟ متاپنوموویروس انسانی و علائم آن
- کاندیدا گلابراتا: زیستگاه، مورفولوژی، پاتوژنز و درمان
- کاندیدا پاراپسیلوزیس: زیستگاه، مورفولوژی، ویژگی ها و پاتوژنز
مترجم: محمد صادق محمودی لرد (LinkedIn) (Google Scholar)





